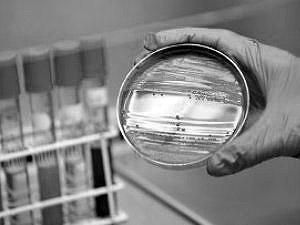
35 человек стали жертвами кишечной инфекции в Германии 35 человек стали жертвами кишечной инфекции в Германии

В заявлении Бара говорится, что он не может исключить того, что это число жертв инфекции увеличится.
"То, что число новых инфицированных снижается, дает определенный повод для оптимизма, но не исключает новых смертельных случаев в будущем ", - сказал немецкий министр.
По данным ВОЗ, число инфицированных превысило 3200 человек в 14 странах Европы, США и Канаде. Санитарно-эпидемиологический надзор Германии утверждает, что источник вспышки инфекции обнаружили в ростках выращенных в стране бобовых культур.